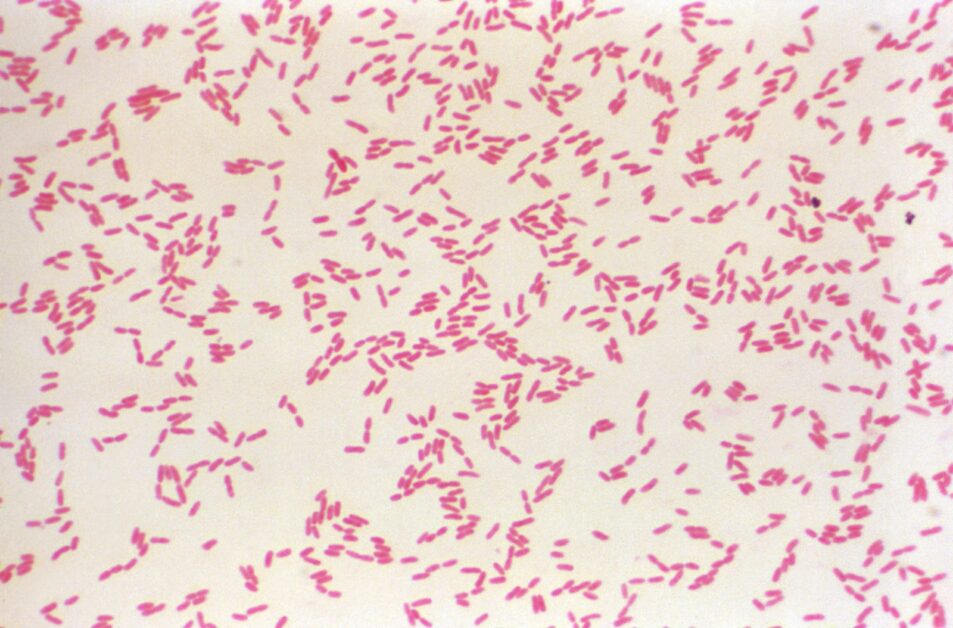

从缅甸病房到“越南定时炸弹”:风灾过后,警惕潜伏在泥土里的类鼻疽
类鼻疽的病原菌是类鼻疽伯克氏菌(Burkholderia pseudomallei),在土壤、水池及积水环境中存在。主要传染途径是皮肤伤口接触到受病原菌污染的土壤或水引起,也可能经由吸入、吃到受污染的土壤或水,或吸入受污染的尘土而受感染,人传人的情况很少发生。
“类”鼻疽又被称为“伪”鼻疽,这是因为它与由鼻疽伯克氏菌(Burkholderia mallei)引起的鼻疽(glanders)在临床症状上相似,都可能导致肺炎、皮肤溃疡与全身性感染。事实上,类鼻疽在首次被观察到时,确实一度被误认为鼻疽;直到经过一连串的培养实验、动物试验与显微镜观察,研究者才确认它其实是全新的病原菌。
意外发现的伪装者
故事要回到 1911 年的英属缅甸仰光。当时的皇家总医院(RGH)仍是木造建筑,病房昏暗潮湿、护理人手短缺。英国病理学家阿弗雷德‧惠特莫尔(Alfred Whitmore)被派驻于此,负责法医检验与末期病患的照护。
在这个资源匮乏的环境,惠特莫尔却坚持医院必须有实验室,因为“诊所与实验室的密切合作,才是高品质医学的基石”,显微镜也成了他探寻病因的武器。
某天,惠特莫尔与助手克里希纳斯瓦米(C.S. Krishnaswami)在一次寻常尸检的病理解剖时,发现一位 40 岁缅甸男子的肺部出现奇特的干酪状病变。这位病患因发烧7天入院,住院3天后死亡;显微镜下的病灶抹片则意外发现了形似鼻疽伯克氏的桿状菌。但这位男子没有马匹的接触史,且刚从监狱被放出来,研判感染鼻疽的可能性极低。
经过进一步培养、观察,惠特莫尔发现这些细菌虽然形似鼻疽桿菌,却具有运动性、能在普通培养基上快速生长;这些表现都与鼻疽桿菌不同。1912 年,他们在《印度医学公报》发表38例病例的系统描述,并将此病命名为“类鼻疽”(melioidosis)。

阿弗雷德·惠特莫尔身着印度医疗服务队制服,约1903年。图片来源:Emerg Infect Dis.
成为“定时炸弹”再入公众视野的致病菌
第一次世界大战后,惠特莫尔被调至英属印度,克里希纳斯瓦米也离开原岗位,类鼻疽逐渐被视为仰光特定人群(例如吗啡成瘾者)的地方性疾病,未引起国际公卫重视,往后的数十年间鲜少再被深入研究。直到20 世纪中期,类鼻疽才因越战再度受到关注。
因类鼻疽伯克氏菌广泛存在于东南亚的土壤与淡水中,当直升机将部队运送到各个角落作战时,扬起的泥土、士兵涉水行军时的皮肤破损,都可能成为感染途径。
部分士兵在感染后长期无症状,病菌可潜伏多年,待免疫力下降时才引发重症。这种延迟发作特性,使得类鼻疽又被称为“越南定时炸弹”(Vietnamese Time Bomb)。
虽然类鼻疽主要在东南亚和澳洲北部盛行,但类鼻疽感染在世界各地均有发生。2021年,美国更曾经发生在香薰喷雾中发现类鼻疽伯克氏菌,并导致了跨洲的感染,显示类鼻疽不再是热带限定的健康威胁。
而与类鼻疽相似的鼻疽桿菌,曾在美国内战、第一次和第二次世界大战被用作生物战武器,加上类鼻疽难以快速诊断,且若不使用特效抗生素快速治疗,患者可能会死亡,也有可能被应用为生物武器。因此美国疾病管制与预防中心 (CDC) 以及其他联邦、州政府正针对类鼻疽的诊断、药品整备制定计划,以应对此类攻击。
这张显微照片采用革兰氏染色技术处理,显示大量革兰氏阴性、桿状的类鼻疽伯克氏菌。图片来源:CDC Public Health Image Library

经鞭毛增强染色处理后,展现了类鼻疽伯克氏菌超微结构形态。图片来源:CDC Public Health Image Library
参考资料:
Whitmore, A. and Krishnaswami, C.S. (1912) An Account of the Discovery of a Hitherto Undescribed Infective Disease Occurring among the Population of Rangoon. Indian Medical Gazette, 47, 262-267.
Brightman, C. and Locum, (2020), Melioidosis: the Vietnamese time bomb. Trends Urology & Men Health, 11: 30-32. https://doi.org/10.1002/tre.753
Diseases: Viet Nam’s Time Bomb(TIME)
CDC Lab Testing Confirms Cause of Melioidosis Outbreak
Melioidosis and Bioterrorism

发表你的评论吧返回顶部
!评论内容需包含中文
